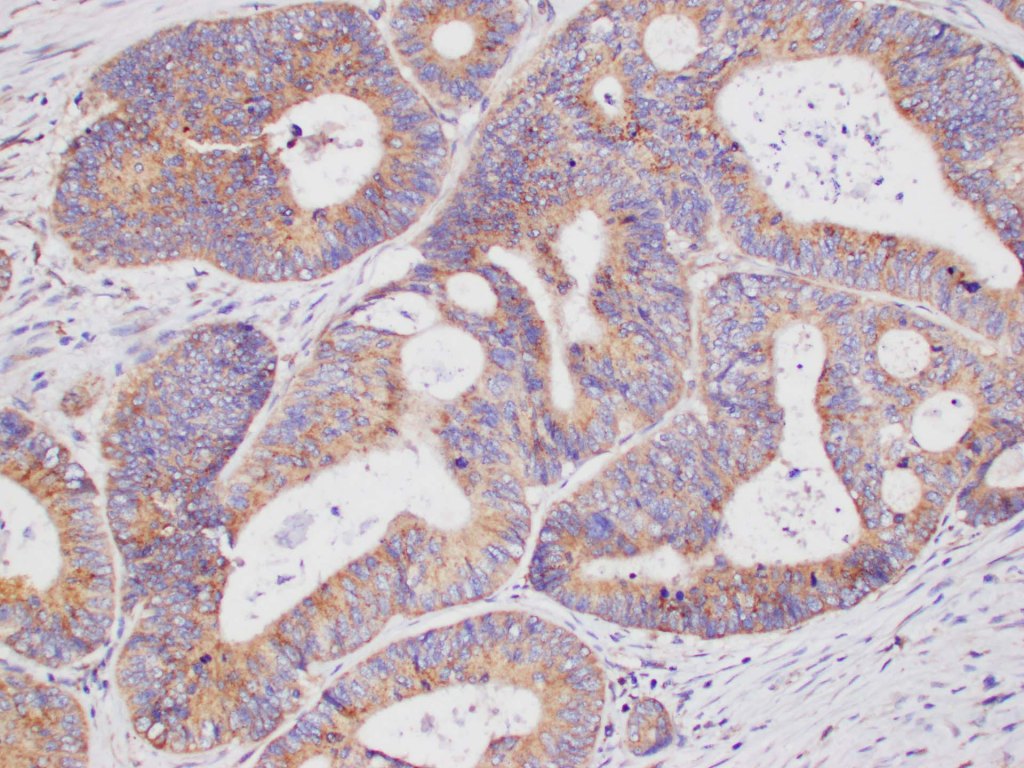

Cancer Initiation and Evolution Laboratory
We seek to understand colorectal cancer across the spectrum from normal, to pre-malignancy, early cancer, and metastatic disease.

Research
Our research encompasses basic science as well as clinical research.
Get in touch for collaborations!
ABOUT US
Find out more about our research team

ALUMNI